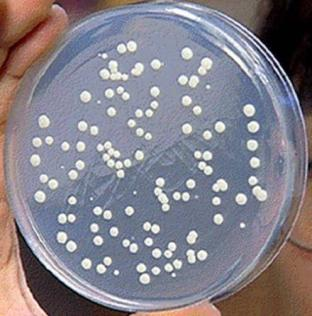
技术资料图片2

北京德航五洲科技有限公司
7 年
手机商铺
商家活跃:
产品热度:
- NaN
- 0
- 0
- 2
- 2
推荐产品
技术资料/正文
培养基如何选择
2008 人阅读发布时间:2022-05-11 14:54
很多科研老师向我们反映,在选购培养基时发现各类培养基产品琳琅满目,不知如何选择。
造成这一选择困难的很大原因是对培养基这类产品的分类不清楚。由于培养基产品有多个分类维度,所以很容易出现不同分类维度概念之间的嵌套交杂,使得老师陷入选择困难。
高效准确的选择适合自己实验的培养基,前提是对培养基的分类有清晰的认识,形成准确的分类逻辑框架。
一:相关基础概念
(一)什么是培养基?
培养基,是指供给微生物、植物或动物(或组织)生长繁殖的,由不同营养物质组合配制而成的营养基质。
(二)培养基一般含有哪些成分?
一般都含有碳水化合物、含氮物质、无机盐(包括微量元素)、生长因子(维生素、氨基酸、碱基、抗菌素、色素、激素和血清等)和水等几大类物质。
(三)培养基的作用?
培养基既是提供细胞营养和促使细胞增殖的基础物质,也是细胞生长和繁殖的生存环境。

(二)根据物理形态分类
展示空间有限,详见下方技术资料↓
造成这一选择困难的很大原因是对培养基这类产品的分类不清楚。由于培养基产品有多个分类维度,所以很容易出现不同分类维度概念之间的嵌套交杂,使得老师陷入选择困难。
高效准确的选择适合自己实验的培养基,前提是对培养基的分类有清晰的认识,形成准确的分类逻辑框架。
一:相关基础概念
(一)什么是培养基?
培养基,是指供给微生物、植物或动物(或组织)生长繁殖的,由不同营养物质组合配制而成的营养基质。
(二)培养基一般含有哪些成分?
一般都含有碳水化合物、含氮物质、无机盐(包括微量元素)、生长因子(维生素、氨基酸、碱基、抗菌素、色素、激素和血清等)和水等几大类物质。
(三)培养基的作用?
培养基既是提供细胞营养和促使细胞增殖的基础物质,也是细胞生长和繁殖的生存环境。

二、培养基分类详解
(一)根据配制原料分类
(一)根据配制原料分类
| 根据配制原料分类 | |||
| 分类 | 来源 | 特点 | 示例 |
| 天然培养基 | 利用动物、植物或微生物体(包括其提取物)制成 | 难以确切知道其化学成分,但一般营养丰富,微生物生长旺盛,而且来源广泛,配制方便,所以较为常用,尤其适合于配制实验室常用的培养基和大生产上的培养基。稳定性常受生产厂或批号等因素的影响。 | 肉膏蛋白胨培养基、麦芽汁培养基、LB培养基 |
| 合成培养基 | 根据天然培养基的成分,用化学物质模拟合成、人工设计而配制 | 用已知化学成分的化学药品配制而成,化学成分精确、重复性强,但价格昂贵,而微生物又生长缓慢,适用于做一些科学研究,例如营养、代谢的研究。 | 高氏1号培养基 查氏培养基 |
| 半合成培养基 | 主要以化学试剂配制,同时还加有某种或某些天然成分 | 在合成培养基中,加入某种或几种天然成分;或者在天然培养基中,加入一种或几种已知成分的化学药品即成半合成培养基。 | 马铃薯蔗糖培养基 |
(二)根据物理形态分类
| 根据物理形态分类 | |||
| 分类 | 特点 | 用途 | 示例 |
| 固体培养基 | 在培养基中加入凝固剂,有琼脂、明胶、硅胶等。 | 常用于微生物分离、鉴定、计数和菌种保存等方面。 | 用于分离微生物的固体培养基 |
| 半固体培养基 | 在液体培养基中加入少量凝固剂而呈半固体状态。 | 可用于观察细菌的运动、鉴定菌种和测定噬菌体的效价等方面。 |  用于观察微生物运动特征的半固体培养基 |
| 液体培养基 | 不加任何凝固剂。成分均匀,微生物能充分接触和利用培养基中的养料。 | 适于作生理等研究,由于发酵率高,操作方便,也常用于发酵工业。 |  用于观察微生物生长状态的液体培养基 |
展示空间有限,详见下方技术资料↓






